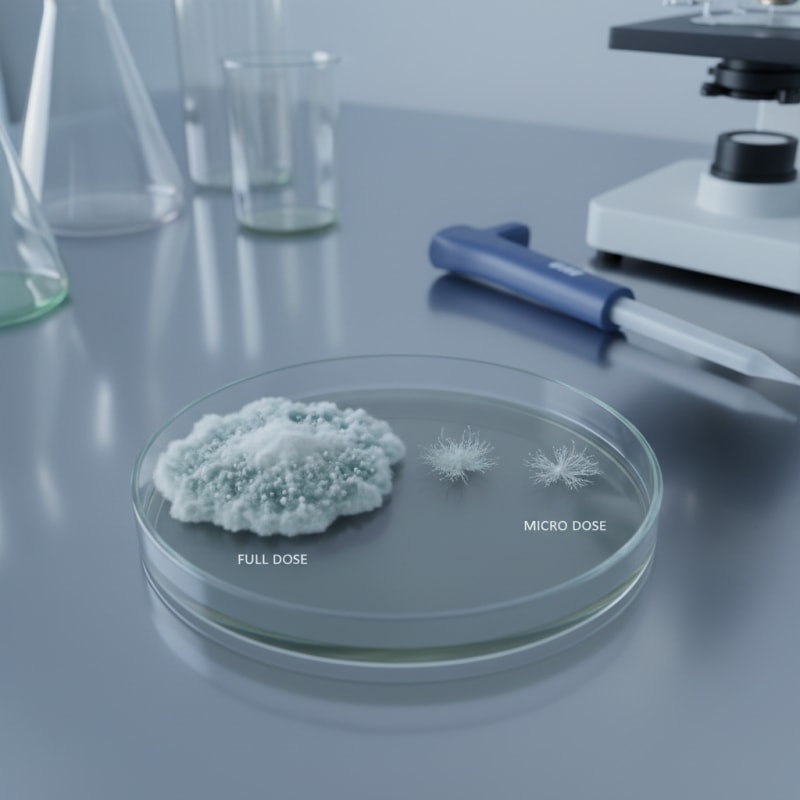
microdosing vs full dose illustration 3

Microdosing vs Full Dosing: What Actually Changes
Quick Summary
Microdosing (0.1–0.3g) targets subtle, sub-perceptual shifts in mood and focus while remaining functional. Full dosing (1.5–3.5g+) produces immersive perceptual and emotional changes that require dedicated time and a supportive setting.

Someone buys capsules labeled 0.2 grams each. Another person buys a 3.5 gram chocolate bar and plans a weekend around it.
Both are using the same underlying material. The experience will not be the same.
The difference starts with quantity, but what changes is not just intensity. It is function.
Microdosing: What Does It Feel Like?
| Attribute | Microdose (0.1–0.3g) | Full dose (1.5–3.5g+) |
|---|---|---|
| Perception | Sub-perceptual | Visuals, time distortion |
| Function | Fully functional | Impaired |
| Duration | 4–6 hours (subtle) | 4–6+ hours (immersive) |
| Intent | Routine integration | Planned session |
| Setting needs | Normal environment | Supportive space |
| Placebo influence | Significant | Less relevant |
At very low doses, often in the range of 0.1 to 0.3 grams of dried psilocybin-containing mushrooms, most people do not report visual distortions or loss of control. The effects, when present, are subtle.
Scientific research on microdosing is still developing, and placebo-controlled studies have shown that expectation plays a meaningful role in perceived benefits.
Full Dosing: What Changes at Higher Amounts?
At higher doses, typically starting around 1.5 to 2 grams and increasing upward, the experience becomes perceptible in more concrete ways. Visual patterning may intensify. Time perception can distort.
The shift is not linear. A person taking 0.2 grams can often work or hold a conversation without difficulty. A person taking 3 grams should not be operating a vehicle.
How Do Onset and Duration Compare?
Onset timing is similar because the compound is the same. Effects typically begin within 20 to 60 minutes. Peak effects usually occur around 1.5 to 3 hours after ingestion. Total duration often falls between 4 and 6 hours.
Why Does Variability Matter More at Lower Doses?
Dried mushrooms vary in potency. Even within the same harvest, active compound concentration can differ.
This is one reason some consumers prefer homogenized formats such as capsules or evenly segmented chocolate bars.
How Does Intent Differ?
Microdosing is often integrated into routine. Full dosing is usually planned. One is structured around maintaining baseline functionality. The other is structured around temporarily stepping outside it.
Thresholds, Not a Sliding Scale
The term "dose" suggests a clean scale from low to high. In practice, it behaves more like thresholds.
Same substance. Different scale. Different consequences for how the day unfolds.
ShroomDash Editorial Team
Published 2026-02-15 · 7 min read · Microdosing



